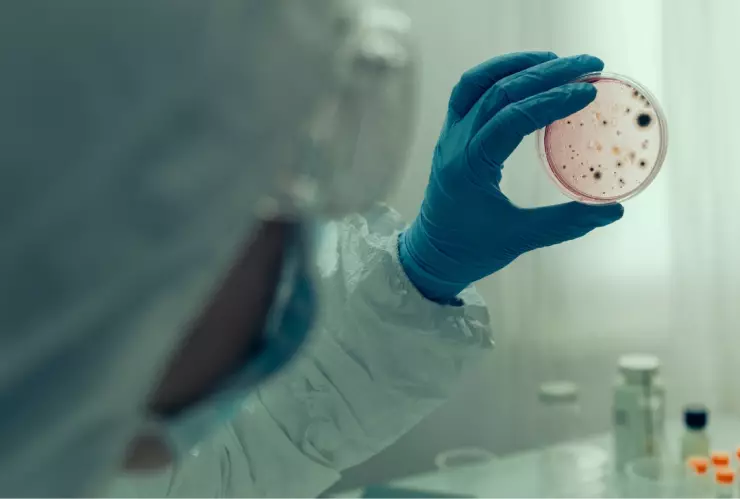
OMS alerta a la población por fuerte aumento de contagios por cólera

Un padecimiento letal ha resurgido de la antigua Roma en todo el mundo, al punto que la Organización Mundial de la Salud ( OMS ) tuvo que emitir una alerta por el excesivo número de contagios y las muertes que ha dejado una de las enfermedades más peligrosas de la historia.
De acuerdo con el comunicado de la agencia sanitaria, la rara enfermedad que acecha el mundo moderno es la cólera, un padecimiento diarréico de nivel agudo resultado de la ingestión de alimentos o agua contaminados. El nombre de la bacteria que causa tal daño estomacal es bacilo Vibrio cholerae, y a pesar de que la medicina actual ha avanzado lo suficiente para contrarrestar sus síntomas, sigue siendo una amenaza global para la salud pública y una de las enfermedades más peligrosas.
Confirman nuevo caso de cólera en Tabasco
El diagnóstico se da luego de 21 años que la entidad se declarara libre de la enfermedad.
Suscríbete a nuestro canal de WhatsApp y lleva la información en la palma de tu mano.
La OMS advierte aumento de contagios de cólera en todo el mundo
Según las estadísticas más recientes de la OMS, los casos de cólera y los decesos que generó crecieron en el 2023. Las cifras en comparación con el 2022 registraron un aumento de 13 por ciento en número de contagios y un 71 por ciento de fallecimientos.
La agencia sanitaria recalcó que en el 2022 se habían reportado 472 mil casos de cólera en todo el mundo y dos mil 250 decesos, sin embargo, en el 2023, se registraron 535 mil contagios y cuatro mil defunciones. De acuerdo con la OMS, estas cifras revelan que la cólera sigue siendo una amenza global para la salud pública y un indicador de "inequidad y falta de desarrollo social".
¿Cuántos países han reportado casos de cólera?
Las muertes comunitarias por
cólera
en todo el mundo alertaron a la OMS, quien recalcó las "graves deficiencias" de salud de dichos países en el acceso a su tratamiento. Al menos 45 naciones reportaron contagios de la bacterua bacilo Vibrio cholerae en el 2023, lo que suma una región más en comparación al 2022. De estos, ocho sufieron grandes brotes, de más de 10 mil contagios sospechosos o confirmados. Los afectados fueron:
- Afganistán
- República Democrática del Congo
- Malaui
- Somalia
- Etiopía
- Haití
- Mozambique
- Zimbabue
Aunque esto supone un cambio significativo en la distribución geográfica del cólera, de 2022 a 2023 disminuyó un 32 por ciento en Oriente Medio y Asia, sin embargo, para el siguiente año, aumentó un 125 por ciento en África.
¿Se han reportado casos de cólera en México?
De acuerdo con el reporte de Vigilancia Epidemiológica, emitido por la Secretaría de Salud (SS), hasta la semana 34 del año en curso, no se han reportado contagios de cólera en México. Asimismo, el acumulado detalla que en el 2023 tampoco se registraron casos, por lo que nuestro país está "libre" de la bacteria bacilo Vibrio cholerae.
Caso contrario, en enfermedades estomacales, México ha registrado más casos de Fiebre tifoidea, Fiebre paratifoidea y salmonelosis que de cólera.
adn40 Siempre Conmigo. Suscríbete a nuestro canal de Telegram y lleva la información en tus manos